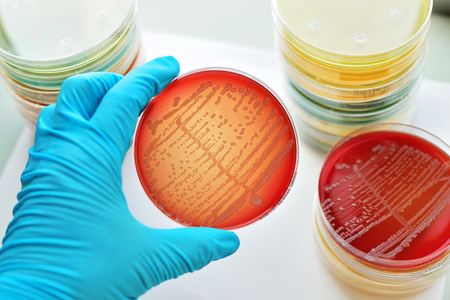

写真素材 - Colonies of bacteria in culture medium plate
キーワード
- Acinetobacter
- Biology
- Blood
- Culture
- Disease
- Escherichia
- Laboratory
- Medical
- Microbiology
- Neisseria gonorrhoeae
- Pseudomonas
- Research
- Science
- Scientific experiment
- Staphylococcus
- aeruginosa
- agar
- antibiotic
- antimicrobial
- aureus
- bacteria
- bacterium
- biochemistry
- chocolate
- coli
- colonies
- colony
- diphtheria
- diplococcus
- gonorrhea
- hemoculture
- identification
- identify
- klebisiella
- macconkey
- media
- medical technology
- medium
- meningitis
- microbial
- mycobacterium
- petri dish
- plate
- pneumoniae
- sepsis
- septicemia
- streptococcus
- test
- testing
- yeast
類似作品
Visualization o...
bacteria colony...
Backgrounds of ...
Bacteria growin...
Macro close up ...
Laboratory petr...
bacteria colony...
close-up of sci...
Close up view r...
microbial cultu...
Dynamic motion ...
Microbiology la...
Petri dishes wi...
Bacteria of dif...
Helicobacter py...
Pills encircle ...
Green mold grow...
close-up of bac...
Cells that caus...
Colorful bacter...
Macro close up ...
Backgrounds of ...
Close up of bac...
Petri dish with...
close-up of bac...
Colonies of dif...
Bacteria macro ...
bacteria colony...
detail of bacte...
Colorful variet...
Close up examin...
Macro close up ...
Backgrounds of ...
A colorful wate...
A close-up of b...
Women scientist...
petri dish with...
Blue bacteria w...
AI Generative
Colonies of dif...
petri dish fill...
Bacteria. Bacte...
Bacteria in a p...
development, re...
Different bacte...
A detailed repr...
Vivid Represent...
Close up of bac...
Macro close up ...